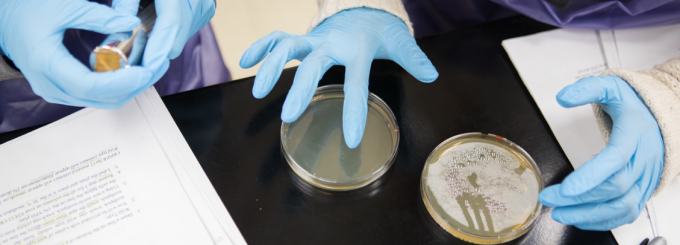
Two undergraduate students wearing blue gloves work with petri dishes on a lab bench, demonstrating CRISPR gene-editing techniques in a biology laboratory.

Genetics explores how genes are turned on and off and how those decisions shape cells, organisms and populations. This research area focuses on the molecular instructions that guide development, behavior and biological function, from single cells to entire species.
Great for students interested in medicine, biotechnology, neuroscience, evolution or molecular biology.
Genetics research asks questions such as:
This research area examines gene regulation at multiple stages, including transcription, RNA splicing, translation and post-translational modification. Genetics also connects molecular processes to larger biological systems, showing how changes at the DNA level influence cells, tissues and whole organisms.
Genetics research spans both molecular and population-level approaches, including:
Together, these approaches reveal how genes operate within cells and evolve across populations.
Genomics, cell and molecular biology, ecology and evolution, neuroscience
Students interested in genetics can engage with research through laboratory work, independent projects and interdisciplinary collaborations that connect genetics to health, evolution and biotechnology.